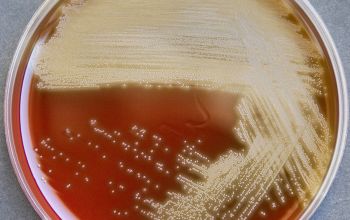

Streptococcus acidominimus
-
General information
General information
S. acidominimus is a member of the viridans group streptococci and is rarely pathogenic in humans making it difficult to assess its epidemiologic and clinical significance.
Taxonomy
Family: Streptococcaceae
Natural habitats
In the bovine vagina, on the skin of calves and in raw milk.
Clinical significance
On rare occasions, it has been associated with infections in human
-
Gram stain
Gram positive streptococci,
grouped in chains Liquid medium,
they are found in the form of chains of different lengths.
They namely divide into one direction
-
Culture characteristics
-
Facultative anaerobic
5% CO2 improves the growth
BA: colonies are 0.5-1.0 mm and α-haemolytic
McConkey: no growth
BBAØ: growth
-
-
Characteristics
-
References
James Versalovic et al.(2011) Manual of Clinical Microbiology 10th Edition
Karen C. Carrol et al (2019) Manual of Clinical Microbiology, 12th Edition